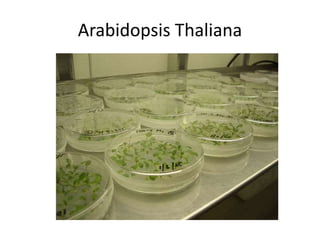
Arabidopsis Thaliana

This document discusses plants, including their characteristics, types, and life cycles. It begins by defining plants and describing some key plant structures. It then separates plants into two main groups: nonvascular and vascular plants. For nonvascular plants, it describes characteristics and provides examples like liverworts and mosses. It explains the alternation of generations life cycle. For vascular plants, it notes the presence of xylem and phloem tissue and describes seedless vascular plant divisions like whisk ferns, club mosses, horsetails and ferns.